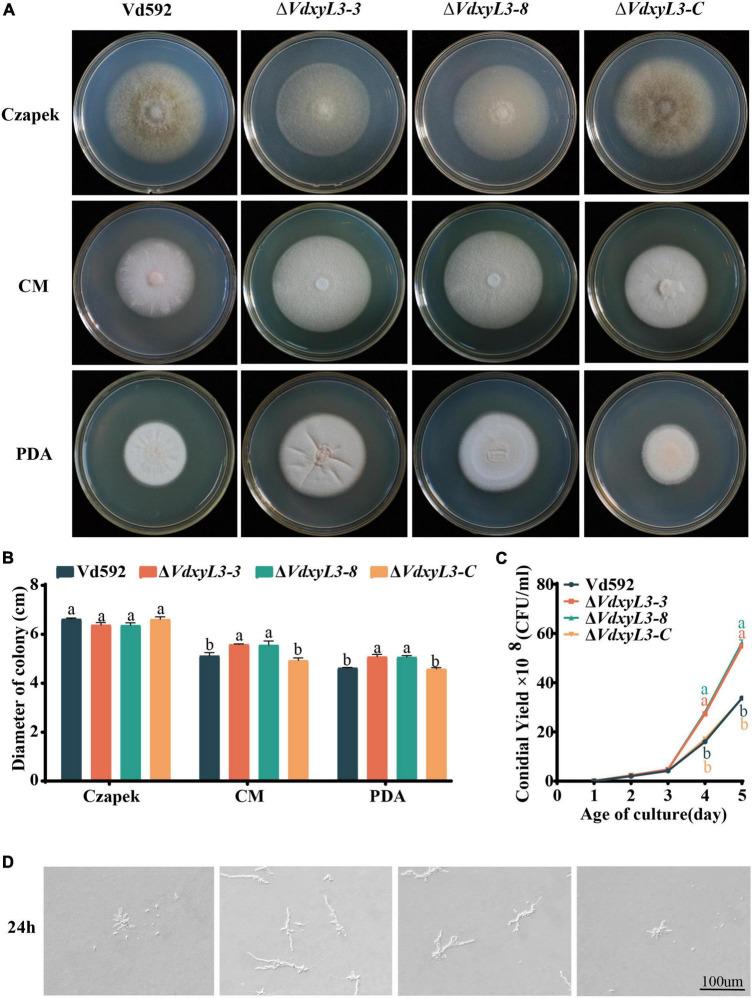
https://cdn.ncbi.nlm.nih.gov/pmc/blobs/b590/11298495/0964536382ac/fmicb-15-1428780-g002.jpg

删除一个编码木糖苷酶的基因会增加……的生长和致病性。 (原文此处“. ”指代不明)
Deleting an xylosidase-encoding gene increases growth and pathogenicity of .
作者信息
Li Yongtai, Song Shenglong, Chen Bin, Zhang Yong, Sun Tiange, Ma Xiaohu, Li Yanjun, Sun Jie, Zhang Xinyu
机构信息
The Key Laboratory of Oasis Eco-agriculture, Agriculture College, Shihezi University, Shihezi, Xinjiang, China.
Key Laboratory of Prevention and Control of Invasive Alien Species in Agriculture and Forestry of the North-western Desert Oasis (Co-construction by Ministry and Province), Ministry of Agriculture and Rural Affairs, Ürümqi, Xinjiang, China.
出版信息
Front Microbiol. 2024 Jul 22;15:1428780. doi: 10.3389/fmicb.2024.1428780. eCollection 2024.
INTRODUCTION
causes a devastating Verticillium wilt disease on hundreds of plant species worldwide, including cotton. Understanding the interaction mechanism between and its hosts is the prerequisite for developing effective strategies for disease prevention.
METHODS
Here, based on the previous observation of an xylosidase-encoding gene () in being obviously up-regulated after sensing root exudates from a cotton variety susceptible to this pathogen, we investigated the function of in the growth and pathogenesis of by generating its deletion-mutant strains ().
RESULTS
Deleting led to increased colony expansion rate, conidial production, mycelial growth, carbon and nitrogen utilization capacities, and enhanced stress tolerance and pathogenicity of . is a secretory protein; however, failed to induce cell death in based on transient expression experiment. Transcriptomic analysis identified 1300 genes differentially expressed (DEGs) between wild-type (Vd952) and during infection, including 348 DEGs encoding secretory proteins, among which contained 122 classical secreted proteins and 226 non-classical secreted proteins. It was notable that of the 122 classical secretory proteins, 50 were carbohydrate-active enzymes (CAZymes) and 58 were small cysteine rich proteins (SCRPs), which were required for the pathogenicity of .
CONCLUSION
The RNA-seq data thus potentially connected the genes encoding these proteins to the pathogenesis of . This study provides an experimental basis for further studies on the interaction between and cotton and the pathogenic mechanism of the fungus.
引言
在全球范围内,包括棉花在内的数百种植物上引发毁灭性的黄萎病。了解[病原体名称]与其宿主之间的相互作用机制是制定有效疾病预防策略的前提。
方法
在此,基于先前观察到[病原体名称]中一个编码木糖苷酶的基因([基因名称])在感知到来自对该病原体敏感的棉花品种的根系分泌物后明显上调,我们通过构建其缺失突变菌株([突变菌株名称])研究了[基因名称]在[病原体名称]生长和致病过程中的功能。
结果
缺失[基因名称]导致[病原体名称]的菌落扩展速率、分生孢子产生、菌丝生长、碳氮利用能力增加,应激耐受性和致病性增强。[基因名称]是一种分泌蛋白;然而,基于瞬时表达实验,[基因名称]未能在[宿主名称]中诱导细胞死亡。转录组分析确定了野生型(Vd952)和[突变菌株名称]在感染期间有1300个差异表达基因(DEGs),其中包括348个编码分泌蛋白的DEGs,其中包含122个经典分泌蛋白和226个非经典分泌蛋白。值得注意的是,在这122个经典分泌蛋白中,50个是碳水化合物活性酶(CAZymes),58个是富含半胱氨酸的小蛋白(SCRPs),它们是[病原体名称]致病性所必需的。
结论
因此,RNA测序数据可能将这些蛋白编码基因与[病原体名称]的致病机制联系起来。本研究为进一步研究[病原体名称]与棉花之间的相互作用以及该真菌的致病机制提供了实验依据。